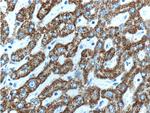
HGS Antibody in Immunohistochemistry (Paraffin) (IHC (P))

Search
Proteintech
HGS Polyclonal Antibody
{{$productOrderCtrl.translations['antibody.pdp.commerceCard.promotion.promotions']}}
{{$productOrderCtrl.translations['antibody.pdp.commerceCard.promotion.viewpromo']}}
{{$productOrderCtrl.translations['antibody.pdp.commerceCard.promotion.promocode']}}: {{promo.promoCode}} {{promo.promoTitle}} {{promo.promoDescription}}. {{$productOrderCtrl.translations['antibody.pdp.commerceCard.promotion.learnmore']}}
产品信息
10390-1-AP
种属反应
已发表种属
宿主/亚型
分类
类型
抗原
偶联物
形式
浓度
规格
纯化类型
保存液
内含物
保存条件
运输条件
产品详细信息
Immunogen sequence: GQIFCGKCS SKYSTIPKFG IEKEVRVCEP CYEQLNRKAE GKATSTTELP PEYLTSPLSQ QSQLPPKRDE TALQEEEELQ LALALSQSEA EEKERLRQKS TYTSYPKAEP MPSASSAPPA SSLYSSPVNS SAPLAEDIDP ELARYLNRNY WEKKQEEARK SPTPSAPVPL TEPAAQPGEG HAAPTNVVEN PLPETDSQPI PPS (186-387 aa encoded by BC003565)
靶标信息
HGS is involved in intracellular signal transduction mediated by cytokines and growth factors. When associated with STAM, it suppresses DNA signaling upon stimulation by IL-2 and GM-CSF. It could be a direct effector of PI3-kinase in vesicular pathway via early endosomes and may regulate trafficking to early and late endosomes by recruiting clathrin. HGS may concentrate ubiquitinated receptors within clathrin-coated regions. It is involved in down-regulation of receptor tyrosine kinase via multivesicular body (MVBs) when complexed with STAM. This complex binds ubiquitin and acts as sorting machinery that recognizes ubiquitinated receptors and transfers them to further sequential lysosomal sorting/trafficking processes. HGS may contribute to the efficient recruitment of SMADs to the activin receptor complex.
仅用于科研。不用于诊断过程。未经明确授权不得转售。
生物信息学
蛋白别名: Hepatocyte growth factor-regulated tyrosine kinase substrate; HGF-regulated tyrosine kinase substrate; HGNC:4897; Hrs; human growth factor-regulated tyrosine kinase substrate; Protein pp110; SNAP-25-interacting protein Hrs-2; unnamed protein product
基因别名: Hgr; HGS; HRS; Hrs2; ZFYVE8
UniProt ID: (Human) O14964, (Rat) Q9JJ50, (Mouse) Q99LI8
Entrez Gene ID: (Human) 9146, (Rat) 56084, (Mouse) 15239